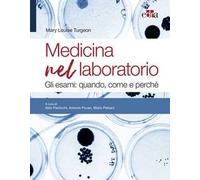
Medicina nel laboratorio. Gli esami: quando, come e perché

🤖 Chiedi a ChatGPT
Informazioni su "come affrontare l'esame"
Confronta 53 confronta per la tua ricerca.
Abbiamo trovatoPricehunter was able to locate prodotti in 11 categorie, a partire da 9,02 € fino a 74,10 €..
I dati relativi "come affrontare l'esame"
- I prezzi più bassi trovati in 5 differenti negozi online, incluso lafeltrinelli.it, ibs.it, Amazon.it e amazon-marketplace.it.
- Dopo aver scelto i tuoi fornitori dovresti anche scegliere la società di consegna. 3 consegne aziende sono disponibili Maven Pharma srl, edra e Euronatur Group s.r.l. essendo la più popolare..
- I più offerte (8) sono stati trovati in fascia di prezzo da 16,00 € a 16,99 €.
- I clienti che hanno cercato questo articolo hanno anche trovato interessante.
- Con la nostra ampia palette di colori puoi selezionare il colore preferito per il tuo articolo. Dei 0 ombre disponibili è quello scelto con più frequenza.